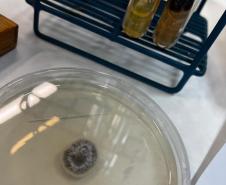
3
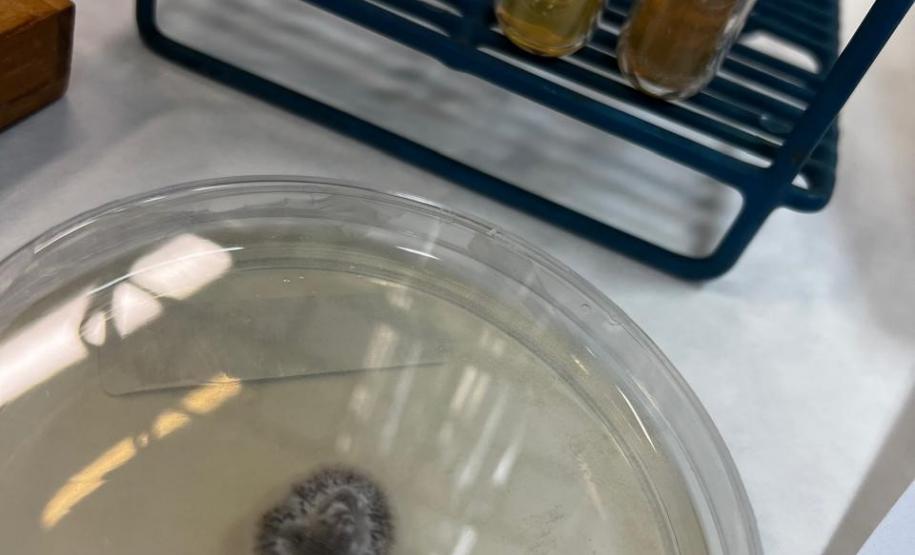
3

Esporotricose no Paraná: ampliação do diagnóstico humano e reforço da vigilância em saúde 26/02/2026 - 14:38
Esporotricose no Paraná: ampliação do diagnóstico humano e reforço da vigilância em saúde
A esporotricose é uma infecção fúngica subcutânea causada por fungos do gênero Sporothrix que pode afetar seres humanos e animais, especialmente gatos. A transmissão ocorre tanto por meio de contato com solo e matéria orgânica contaminados quanto por arranhaduras, mordidas ou contato direto com lesões de felinos infectados — forma que tem sido predominante em ambientes urbanos e periurbanos no Brasil.
Panorama epidemiológico no Paraná
Com a publicação da Resolução SESA nº 93/2022, que tornou a esporotricose de notificação compulsória no estado para humanos e animais, o Paraná consolidou sua vigilância epidemiológica, permitindo a identificação e monitoramento mais precisos dos casos.
As regionais metropolitanas de Curitiba, Foz do Iguaçu e Paranaguá foram as que apresentaram as maiores incidências.
Estudos epidemiológicos e séries históricas indicam que, ao longo da última década, houve aumento contínuo da esporotricose em municípios do estado, especialmente na região metropolitana de Curitiba, refletindo a necessidade de uma vigilância integrada e contínua com abordagem de uma só saúde.
Ampliação do diagnóstico laboratorial humano pelo LACEN/PR
O Laboratório Central do Estado do Paraná (LACEN/PR), referência para análises epidemiológicas no Paraná, ampliou sua capacidade diagnóstica disponibilizando, além do diagnóstico em animais de pequeno porte, o diagnóstico em amostras humanas, conforme critérios pré-estabelecidos em conjunto com a Divisão Ambiental da Secretaria de Saúde do Estado do Paraná (SESA).
Os métodos diagnósticos também sofreram mudanças, além do método de cultura para fungos (considerado padrão-ouro), seguida de identificação do microrganismo por método proteômico (MALDI TOF MS) que se restringe à identificação do gênero, o laboratório implantou técnica molecular (qPCR) para diferenciação das duas espécies prevalentes no Brasil: S. schenckii e S. brasiliensis.
Neste sentido, hoje, o LACEN/PR disponibiliza:
- Exame por cultura fúngica – que permite o crescimento e isolamento do fungo Sporothrix a partir das amostras clínicas, confirmando a presença do agente etiológico.
- Diagnóstico molecular por qPCR (Reação em Cadeia da Polimerase em tempo real) – que confirma a espécie envolvida com elevada sensibilidade e especificidade, possibilitando a identificação precisa de Sporothrix brasiliensis, que é a espécie mais frequentemente associada à transmissão zoonótica em surtos urbanos no Brasil.
Esse avanço fortalece a vigilância laboratorial e epidemiológica, reduz o tempo entre suspeita clínica, confirmação laboratorial e início do tratamento adequado, além de possibilitar uma resposta mais célere das equipes de saúde pública.
Importância da atuação integrada e medidas de controle
A esporotricose representa um desafio de saúde pública devido à sua natureza zoonótica e ao envolvimento de múltiplos setores – saúde humana, saúde animal e meio ambiente. A atuação integrada entre serviços de atenção primária à saúde, vigilância epidemiológica, medicina veterinária e laboratórios de referência é essencial para:
- Identificar precocemente casos humanos e felinos.
- Adotar medidas de controle nos territórios com maior carga de transmissão.
- Orientar a população sobre prevenção e manejo responsável de animais domésticos.
- Reduzir a transmissão cruzada entre animais e humanos.
Prevenção e orientações à população
As principais recomendações para reduzir o risco de transmissão incluem:
- Evitar contato direto com lesões de gatos com sinais clínicos compatíveis com esporotricose.
- Utilizar equipamentos de proteção (luvas) ao manusear animais suspeitos.
- Buscar atendimento médico diante de lesões cutâneas persistentes ou com evolução sugestiva da doença.
- Encaminhar gatos com lesões suspeitas para avaliação veterinária e tratamento adequado.
- A vigilância contínua e a ampliação dos recursos diagnósticos são fundamentais para proteger a saúde da população paranaense, garantindo respostas adequadas e baseadas em evidências científicas frente à esporotricose.